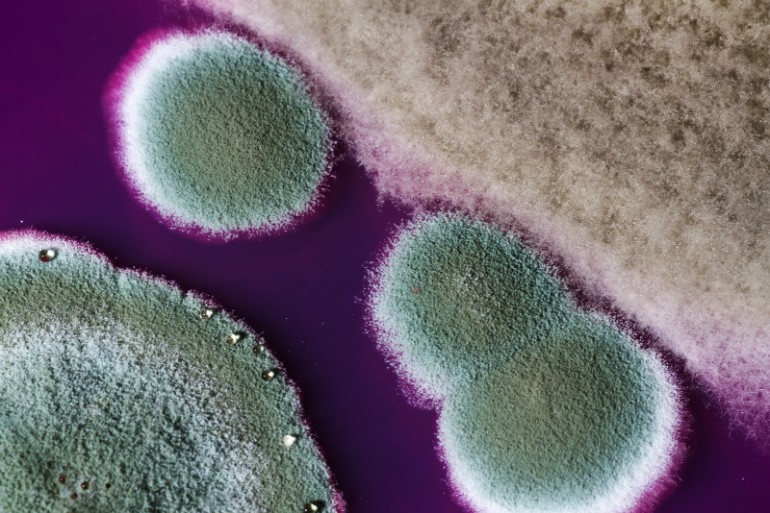
A penész belélegzése légúti panaszokat okozhat.

Ha látszólag minden ok nélkül, hosszabb ideje tartó orrdugulás, köhögés gyötri a lakásban, ideje benéznie a szekrények, falvédők mögé!
A mennyezeten, az ablakok, vagy a bejárati ajtó sarkaiban megbúvó penész könnyen észrevehető és igyekszünk is mihamarabb megszabadulni tőle. De mi a helyzet azokkal, amiket nem látunk?
Új vagy régi - a penész nem válogat
A penészedés problémájára sokan még mindig úgy gondolunk, mint a régi építésű, felújításra szoruló házakban, pincékben jelentkező jelenségre. A penész azonban bárhol megjelenhet, ahol megtelepedéséhez ideális feltételeket talál. Legyen az az újépítésű otthon rosszul szigetelt fala, vagy az ágy mellé helyezett falvédő mögötti terület - magyarázza dr. Magyar Donát, aerobiológus.
Ha a tégla építésű családi ház túl gyors ütemben épült, a száradási idő a beköltözés utáni időkben zajlik majd, az így kialakult magas páratartalom pedig kedvez a penészgombák megtelepedésének. A könnyűszerkezetes házak falain, megfelelő szigetelés hiányában, szintén gyakran tapasztalható a nem csak esztétikailag zavaró jelenség.
Az egészséget is veszélyezteti a penész
A magas páratartalom egyaránt kedvez a penészgomba és a házi poratka megtelepedésének. Magas koncentrációban mindkét "társbérlő" súlyos allergiás panaszokat okozhat, melyek gyakran csak későn, a szövődmények megjelenésekor kerülnek felismerésre. - hívja fel a figyelmet dr. Balogh Katalin allergológus, fül-orr-gégész, a Budai Allergiaközpont főorvosa.
A betegek tévesen, gyakran megfázásként kezelik a téli időszakban jelentkező panaszokat. Kezdetben légúti irritációt, orrdugulást, köhögést tapasztalnak, megfelelő kezelés hiányában pedig az elhúzódó panaszok következtében idült arcüreggyulladás is kialakulhat.
A tünetek felismerése, a valódi kiváltó okok tisztázása és megszüntetése nélkül a lakáson belüli allergének által kiváltott panaszok kezelése azonban nem valósulhat meg.
Ismert penész lelőhelyek a lakásban
A penészgomba a magas páratartalom mellett különösen kedveli a hűvös, sötét zugokat, felkutatására indított expedíciónkat ezért érdemes ehhez hasonló helyeken kezdenünk. Amit mindenképp vizsgáljunk át:
- a fürdőszobai mosdó alatti részen, kád mellett,
- a szobanövények cserepeiben,
- a konyhában, a mosogató mögötti területeken,
- ajtók, ablakok környékén.
A penész belélegzése légúti panaszokat okozhat.
Forrás: Napidoktor
A gipszkarton fal és a tapéta is gyanús lehet- mögöttük is megbújhat a penész
A lakásban akkor is magas lehet a gombaspórák koncentrációja, ha penésznek látszólag nyoma sincs. A probléma ilyenkor gyakran a ház szerkezetén belül, például a gipszkarton falak mögötti területen jelentkezik. Ilyen esetekben a penészedésnek látható jele ugyan nincs, de a gipszkarton mikrorepedésein átjutó spórák miatt a házban élőknél légúti panaszok jelentkezhetnek.
Nem csak a látványos helyeken jelenhet meg a penész: sőt, érdemes körbenézni a bútorok mögött is. A spórák akár a tapéta alatti területeken is megtelepedhetnek, különösen kedvelt számukra a fűrészporos tapéta által biztosított környezet. Ilyen esetekben a tapéta alatt megindult penészesedésre gyakran csak egy-két gyanús folt, elszíneződés figyelmeztet.
A lakásban lévő hangszigetelés, vagy álmennyezet is számos gombatelepet rejthet. A külső, különösen az északi falakra helyezett ágyak, beépített szekrények, falvédők és képek mögötti területek átvizsgálása során is penészgomba telepekre lelhetünk.
Penész: a nagy átalakítás előtt
Mielőtt a lakás teljes átépítéséhez fognánk, nem árt, ha tudjuk a penész honnan is ered. Véletlen balesetek – kiömlött víz, üdítő, vagy egyszeri beázás – esetén ugyanis a penésztől sikeresen megszabadulhatunk, ha a kiváltó okok megszüntetése után az érintett falfelületet hígított hypo-oldattal tisztára töröljük.
Bonyolultabb esetekben, ha nem tudjuk, hogy valójában mi okozza a penészedést, vagy a tisztítás ellenére a probléma kiújulásával találkozunk, célszerű szakszerű segítséget kérnünk.
Nehézlégzés, köhögés: nem csak koronavírus, asztma jele is lehet!
A rejtett penész búvóhelye a lakásban elvégzett mintavétel segítségével könnyen azonosítható, így a felújítást ezután közvetlenül a probléma forrásának helyén kezdhetjük meg. Megoldásként elképzelhető, hogy a magas páratartalmat kiváltó műanyag – és egyben párazáró tulajdonságú - beltéri falfestéket kell majd eltávolítanunk, vagy a külső falra helyezett bútorokat kell elhúznunk a faltól, hogy a folytonos szellőzést biztosítsuk.
Nagyobb beavatkozást igényel, ha a gondot a ház rossz szigetelése okozza, ezt semmiképp sem ajánlott házilag orvosolnunk, mivel az utólag végzett belső szigetelés szintén a penészgombák megtelepedéséhez vezethet. A nagyobb munkálatok megkezdése előtt célszerűbb tehát, ha pontosan ismerjük a probléma kiváltó okát.
Olvasta már?
- Allergia elleni szer: miért nem hatásos idén, ha tavaly még jó volt?
- Allergiás? Ha ezt tapasztalja, azonnal forduljon orvoshoz
- Náthás vagy allergiás? Így derítheti ki
- Anafilaxiás sokk: így kell használni az életmentő epinefrin injekciót
- Allergia: fejfájást is okozhat
Penészallergia: ezek a tünetek jelzik
Kövesse az Egészségkalauz cikkeit a Google Hírek-ben, a Facebook-on, az Instagramon vagy a X-en,Tiktok-on is!










